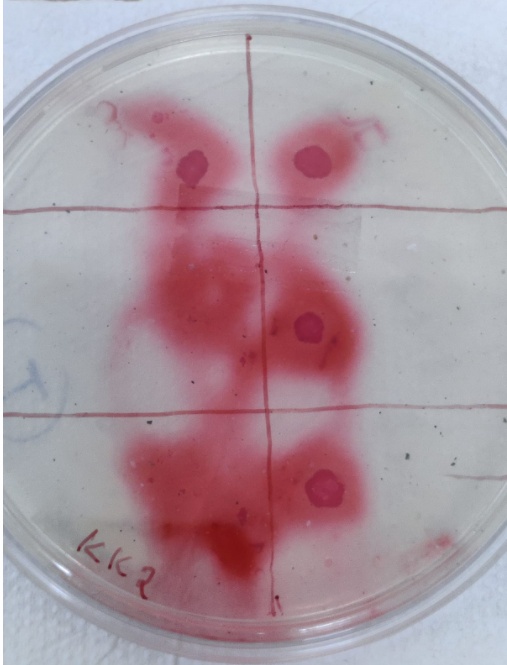

Int J Pharm Pharm Sci, Vol 15, Issue 4, 22-27Original Article
ISOLATION AND CHARACTERIZATION OF CELLULOSE-DEGRADING BACTERIA FROM DECOMPOSING PLANT MATTER
HEMA J. N.1, SHOBHA2, SHRUTHI S. D.3*
1Department of Biotechnology, M. S. Ramaiah Institute of Technology, Bangalore 560054, 2Department of Botany, University College, Mangaluru 575001, Karnataka, India, 3Microbiology and Molecular Biology Lab, BioEdge Solutions, Bengaluru, Karnataka, India
Email: services@bioedgesolutions.com
Received: 07 Dec 2022, Revised and Accepted: 03 Mar 2023
ABSTRAC
Objective: The green plant waste consists of a high amount of lignocellulosic materials offering an intense environment for the growth of cellulolytic bacteria, which have ability to degrade plant biomass as a carbon source. This cellulase produced can be used to break down plant waste into valuable products such as monomeric sugars, biofuels, compost etc. Therefore, the aim of present study was to isolate and identify potent cellulose-degrading bacteria from decomposing plant matter and assessment of their cellulolytic activity.
Methods: The cellulolytic bacteria were isolated by serial dilution technique on CMC agar media and six isolates were selected based on their cellulose hydrolysing ability. Based on the biochemical tests such as Oxidase test, Voges-Proskauer test, Methyl red test, Catalase test and sequence analysis of 16s rRNA genes.
Results: The isolates were identified as Paenibacillus alvei, Paenibacillus lentimorbus, Bacillus subtilis, Bacillus nakamurai with percentage identity of 93.77%, 92.80%, 97.71% and 91.94%, respectively, as obtained from NCBI BLAST. Among these Paenibacillus alvei showed the highest cellulase activity.
Conclusion: The findings of this study could pave the way for the use of cellulose as an inexpensive energy source for bacteria that are capable of producing valuable products.
Keywords: Cellulose-degrading bacteria, Cellulase, Carboxymethyl cellulose, Green plant waste, 16s rRNA
© 2023 The Authors. Published by Innovare Academic Sciences Pvt Ltd. This is an open access article under the CC BY license (https://creativecommons.org/licenses/by/4.0/)
DOI: https://dx.doi.org/10.22159/ijpps.2023v15i4.47019. Journal homepage: https://innovareacademics.in/journals/index.php/ijpps.
INTRODUCTION
Cellulose is a complex carbohydrate composed of a linear chain of β-1,4 linked d-glucose units and is the most abundant organic polymer on the earth. It is the basic structural component of plant cell walls, wood, and numerous forms of algae [1]. Cellulose is a cheap biopolymer and almost inexhaustible raw material available today worldwide. The unique properties of cellulose are a result of its unique structure. Cellulose is a crystalline solid that is hydrophilic and biodegradable [2]. Cellulose is a massive renewable bioresource synthesized by a photosynthetic process. The green plant waste consists of a high amount of lignin, hemicellulose, and cellulose. So, the degradation of green plant waste is difficult and requires more time. The cellulose and other various compounds present in the organic waste can be broken down by microbial enzymes to produce economically valuable products such as monomeric sugars, microbial biomass proteins, compost, biofuels, antibiotics, and so on [3]. Hence, the use of microbial enzymes to degrade plant biomass has many physiological, industrial, and environmental applications [4].

Fig. 1: Microbial degradation of cellulose [2]
The biological degradation of cellulose by several cellulolytic enzymes, collectively known as cellulase enzymes has attracted the interest of biotechnologists for many years. These enzymes are produced chiefly by several microorganisms such as bacteria, fungi, and protozoans during their growth on cellulosic materials [5]. The degradation of cellulose is the result of a synergic process between three major enzymes endoglucanases (EC 3.2.1.4), exoglucanases (EC 3.2.1.91), and β glucosidase (EC 3.2.1.21) [6]. The combined action of endoglucanase, exoglucanase, and β-glucosidase determine the efficiency of the cellulolysis process. Endoglucanases released by bacteria cleave the β-1,4-glycosidic linkages of cellulose, releasing oligosaccharides of variable lengths. Subsequently, Exoglucanases act on the endoglucanases-generated chain ends to liberate glucose or cellobiose molecules. Cellobiose is finally hydrolysed to two glucose molecules by β-glucosidases [7]. Bacteria are now being explored for cellulase production due to their higher growth rate, stability at different temperatures and pH, lower feedback inhibition, production of multienzyme complexes and ability to grow in a wide range of environmental conditions [8]. Cellulase has potential applications in the detergent industry, food processing industry, agriculture, pulp and paper industry and biofuel production [9]. Isolating potential strains is the first step in developing an industrial process for the production of an enzyme. Isolation and identification of microbes for cellulases are critical, given the high demand for new enzymes and the advancement of their biotechnological applications.
The main objective of this study was the isolation and identification of cellulose-degrading bacteria from decomposing plant waste and the assessment of their cellulolytic activity.
MATERIALS AND METHODS
Sample collection
The decomposing plant waste was collected from Gruhalakshmi Layout BBMP park in Bangalore and was brought to the Bioedge solutions laboratory for the isolation of cellulose-degrading bacteria.
Isolation of cellulose-degrading bacteria
Cellulolytic bacterial strains were isolated from decomposing plant waste by serial dilution and direct plating method [10]. The collected sample was serially diluted and dilutions were made up to 10-5. About 1 ml of inoculum from serially diluted samples were spread on CMC (carboxymethyl cellulose) agar plate thoroughly and incubated at 37 °C for 24 h. Later 6 isolates that showed growth on the CMC plate were selected for further study [11].
Screening of CDB strains
The 6 isolated cellulose-degrading bacterial strains were screened for determination of cellulase activity. The Six CDB isolates were transferred to CMC agar plates. After incubation for 24 h, CMC agar plates were flooded with safranin solution and allowed to stand for 20 min at room temperature. Later, 1M NaCl was used for counterstaining the plates. The plates were flooded with 1M NaCl for 20 min. After discarding the NaCl, clear zones appeared around the bacterial colonies indicating cellulose hydrolysis [12].
Determination of cellulase activity
Enzyme cellulose activity of 6 CDB isolates was measured by the phenol-sulphuric method through the determination of the reducing sugars liberated from carboxymethyl cellulose [13].
The culture broth was centrifuged at 5000rpm for 5 min and the clear supernatant was collected as crude enzyme for enzyme assay. Then, 0.2 ml of the crude enzyme was added to 1.8 ml of 0.5% CMC in 50 mmol sodium phosphate buffer and incubated at 50 ᵒC for 30 min. After incubation, 5% phenol was added to the reaction mixture. The reaction mixture was then kept at room temperature for 20 min. Sugars liberated were determined by measuring the absorbance at 490 nm. The cellulase activity was determined by a using glucose calibration curve.
Morphological and biochemical characterization of CDB strains
The isolates were examined for morphological features by Gram’s staining technique. The biochemical properties of the isolates were determined by oxidase test, Voges-Proskauer test, Methyl red test and Catalase test [14].
DNA isolation and PCR amplification
The bacterial genomic DNA was extracted by the CTAB extraction method. The selected 6 CDB isolates were grown overnight on a CMC agar plate. A loopful of culture was resuspended in 1 ml of CTAB extraction buffer and was mixed thoroughly by pipetting in and out. The samples were incubated at 60 ᵒC for 30 min. Following the incubation, centrifugation was done for 5 min at 14,000 rpm. Then, an equal volume of chloroform/isoamyl (24:1) alcohol was added. The samples were vortexed for 5 seconds and then centrifuged at 14000rpm for 5 min to separate the phases. The upper aqueous phase was transferred to a new tube and the DNA was precipitated by adding isopropanol. The mixture was transferred to the silica-based DNA-based column and spun at 12,000rpm for 1 minute. Then the samples were washed repeatedly using a wash buffer. The DNA was eluted by adding elution buffer and the RNA was removed by adding RNA ase. The DNA obtained was quantified by the gel electrophoresis method. The extracted DNA was amplified by a polymerase chain reaction. The PCR reaction mixture was as follows: 1µ1 of template DNA, 1 µl of 10 µM universal 16s rRNA forward primer 27F (5′ AGA GTT TGA TCC TGG CTC AG 3′) and 1 µl reverse primer 1429R (5′ TAC GGT TAC CTT GTT ACG ACTT 3′) (Raw way et al., 2018 and Xue 2020). 0.5 µl of Taq polymerase, 10µM of 1 µl dNTP’s, 2.5 µl of buffer, and 1.8 µl of nuclease-free water. The thermal cycle profile was as follows: 5 min initial denaturation at 95 ᵒC, 35 cycles of 30 seconds final denaturation, annealing at 55 ᵒC for 30 seconds, elongation at 72 ᵒC for 1 minute, followed by final elongation for 5 min. The PCR products were analysed in agarose gel electrophoresis stained with ethidium bromide.
DNA sequencing and data analysis
The PCR amplified 16S rDNA region using 16S rDNA primers of 6 CDB isolates were sequenced using an automated DNA sequencer. The 16S rDNA gene sequences obtained were compared with previously submitted 16S rDNA sequences available in Genbank at the National Centre for Biotechnology using the nucleotide BLAST (blastn) program and aligned with similar sequences using an online tool CLUSTAL Omega [15, 16].
RESULTS
Six bacterial strains were isolated from the decomposing plant matter and were screened for cellulase production using a CMC medium. All 6 bacterial isolates showed clear zones around their colonies on cellulose medium, indicating that these microbes have the ability to degrade cellulose by producing cellulase enzyme (fig. 2).
The quantitative measurement of the cellulase production was carried out by measuring the amount of reducing sugar liberated from CMC media by 6 bacterial isolates using the phenol sulphuric acid method. The glucose concentration was liberated by six CDB isolates was 0.6286, 0.8089, 0.3647, 0.191, 0.705, 0.563 mg/ml, and the enzyme activity was 1.16, 1.49, 0.674, 0.353, 1.04 mmol/(min. ml) respectively. In this study, CDB-2 liberated the highest glucose concentration 1.496 mg/ml in the medium and showed the highest enzyme activity 0.8089 mmol/(min. ml).
The morphological characteristics of the isolates were determined by the Gram’s staining test. All the six CDB isolates retained the purple colour and appeared as rod-shaped bacteria when observed under a microscope, which shows they are gram-positive organisms. The morphological and biochemical features of the isolates are presented in table 1.
For further identification, genomic DNA was isolated and the 16S rRNA gene was amplified and sequenced. The DNA size of the amplified 16S rRNA gene was estimated by electrophoresis using a 100bp DNA Ladder as a DNA marker. The electrophoresis result (fig. 5) showed that all isolates contain a 1200bp size of 16S rRNA gene. The 16S rRNA gene sequence of each isolated bacteria was compared with the present 16S rRNA gene sequences in the Genebank via Nucleotide BLAST to identify the most similar sequence alignment. The phylogenetic tree of the isolated strains and closely related strains was constructed using the CLUSTAL Omega tool (fig. 6). The results of 16S rRNA gene sequence analysis of the 6 CDB strains revealed that they are closely related to Bacillus species, Paenibacillus alvei, Paenibacilluslentimorbus, Bacillus subtilis, Bacillus nakamurai (table 2).
Fig. 2: Hydrolysing zones produced by bacterial strains on agar plates containing CMC

Fig. 3: Gram’s staining results

Fig. 4: Genomic DNA bands of the isolated CDB strains

Fig. 5: PCR amplified 16S rRNA gene bands of the isolated CDB strains

Fig. 6: Phylogenetic analysis of cellulose-degrading bacteria with closely related strains based on 16s rRNA gene sequence
Table 1: Results of morphological and biochemical tests of isolated cellulose-degrading bacterial colonies
| Isolate no. | Gram’s staining | Catalase test | Oxidase test | Voges-Proskauer test | Methyl red test |
| CONTROL | - | - | - | - | + |
| CDB-1 | + | + | + | + | + |
| CDB-2 | + | + | - | + | + |
| CDB-3 | + | + | - | + | + |
| CDB-4 | + | + | + | + | - |
| CDB-5 | + | + | - | + | + |
| CDB-6 | + | + | - | + | + |
Table 2: BLAST N results of 16s rRNA gene of isolates
| Isolates | Closest strain in NCBI database | Query cover (%) | E-value | Ident (%) | Accession number |
| CDB-1 | Bacillus sp. | 96 | 3e-176 | 94.62 | MK249928.1 |
| CDB-2 | Paenibacillus alvei | 79 | 8e-158 | 93.77 | MN543811.1 |
| CDB-3 | Paenibacillus lentimorbus | 93 | 0.0 | 92.80 | AY860842.1 |
| CDB-4 | Bacillus subtilis | 86 | 0.0 | 97.71 | KY063700.1 |
| CDB-5 | Bacillus sp. | 76 | 0.0 | 97.12 | LCA24415.1 |
| CDB-6 | Bacillus nakamurai | 84 | 0.0 | 91.94 | MN737999.1 |
DISCUSSION
In the present study, 6 cellulose-degrading bacteria were isolated from decomposing plant waste. The results of morphological, biochemical characterization together with the results of 16S rRNA gene sequence analysis of the 6 CDB strains revealed that the isolates are gram-positive bacteria and they were closely related to Bacillus species, Paenibacillus alvei, Paenibacilluslentimorbus, Bacillus subtilis and Bacillus nakamurai. In our study, the genus Bacillus was found to be the main cellulose-degrading bacteria in the decomposing plant waste. Similarly, Bacillusspecies have been reported to be the dominant cellulose-degrading bacteria in samples collected from biogas slurry, industrial samples and the gut of insects [17, 18].
The cellulase activity of the CDB isolates was higher than 0.071±0.01 IU/ml of cellulase activity for Bacillus species isolated from organic manure [19]. Many studies have reported that the cellulase activity of the cellulose-degrading bacteria can be enhanced by optimizing the growth conditions and the carbon and nitrogen sources [20, 21]. In our study, Paenibacillus alvei showed the highest cellulase activity. Similarly, the Paenibacillus species isolated from sawdust and coffee residue compost also showed good cellulase activity [22]. The Bacillus species possess cellulose-hydrolytic activity. They have the ability to produce β-glucosidases, hemicellulases, and endoglucanases [23]. The genus Bacillus has a highly conserved 16S rRNA gene sequence that can be used to identify the bacteria. Paenibacillus species are efficient cellulase producers. They have the ability to digest cellulose and hemicellulose by producing enzyme complexes [24]. Bacillus subtilis have the ability to produce a good quantity of exocellulase and endo cellulase enzymes and can grow in different environments [25]. However, there is not enough information available on cellulose degradation by the Bacillus nakamurai strain.
CONCLUSION
Six cellulose-degrading bacteria were isolated from decomposing plant matter using CMC medium and their cellulase activity was evaluated. The morphological, biochemical and molecular characterization of the isolated CDB strains revealed that they are closely related to Bacillus species, Paenibacillus alvei, Paenibacillus lentimorbus, Bacillus subtilis, Bacillus nakamurai. The CDB-2 strain showed the highest cellulase activity among the 6 isolated strains. Thus, this study reveals that all six cellulose-degrading bacteria isolated from the decomposing plant matter can efficiently produce cellulase enzyme, which could be used for various industrial applications. Further study on the optimization of various factors, such as medium additives and growth conditions for large-scale production of cellulase to use in industrial applications, is needed.
ACKNOWLEDGEMENT
Hema has executed the research. Dr. Shruthi S. D has guided in carrying out the project and framing the research article. Dr. Shobha is a botanist who has helped in selecting authenticated plant materials for carrying out the research.
FUNDING
Nil
AUTHORS CONTRIBUTIONS
All the authors have contributed equally.
CONFLICT OF INTERESTS
Declared none
REFERENCES
-
Sundarraj AA, Ranganathan TV. A review on cellulose and its utilization from agro-industrial waste. Drug Invent Today. 2018;10(1):89-94.
-
Lakhundi S, Siddiqui R, Khan NA. Cellulose degradation: a therapeutic strategy in the improved treatment of acanthamoeba infections. Parasit Vectors. 2015;8(1):23. doi: 10.1186/s13071-015-0642-7, PMID 25586209.
-
Hussain AA, Abdel Salam MS, Abo Ghalia HH, Hegazy WK, Hafez SS. Optimization and molecular identification of novel cellulose-degrading bacteria isolated from Egyptian environment. J Genet Eng Biotechnol. 2017;15(1):77-85. doi: 10.1016/j.jgeb.2017.02.007, PMID 30647644.
-
Kaur M. Isolation and screening of cellulose-degrading bacteria in kitchen waste and detecting their degrading potential. IOSRJMCE. 2012;1(2):33-5. doi: 10.9790/1684-0123335.
-
Zhang XZ, Zhang YHP. Cellulases: characteristics, sources, production, and applications. Bioprocess Technol Biorefin Sustain Prod Fuels Chem Polym. 2013;1:131-46.
-
Dar MA, Shaikh AA, Pawar KD, Pandit RS. Exploring the gut of Helicoverpa armigera for cellulose-degrading bacteria and evaluation of a potential strain for lignocellulosic biomass deconstruction. Process Biochem. 2018;73:142-53. doi: 10.1016/j.procbio.2018.08.001.
-
Jayasekara S, Ratnayake R. Microbial cellulases: an overview and applications. Cellulose. 2019;22.
-
Mahmood R, Afrin N, Jolly NS, Shilpi YR. Isolation and identification of cellulose-degrading bacteria from different types of samples. World J Environ Biosci. 2020;9(2):8-13.
-
Ejaz U, Sohail M, Ghanemi A. Cellulases: from bioactivity to a variety of industrial applications. Biomimetics (Basel). 2021;6(3):44. doi: 10.3390/biomimetics6030044, PMID 34287227.
-
Singh S, Jaiswal DK, Sivakumar N, Verma JP. Developing efficient thermophilic cellulose-degrading consortium for glucose production from different agro-residues. Front Energy Res. 2019;7:61. doi: 10.3389/fenrg.2019.00061.
-
Ahmad B, Nigar S, Shah SA, Bashir S, Ali J, Yousaf S. Isolation and identification of cellulose-degrading bacteria from municipal waste and their screening for potential antimicrobial activity. World Appl Sci J. 2013;27(11):1420-6.
-
Dubey SK, Meena RK, Sao S, Patel J, Thakur S, Shukla P. Isolation and characterization of cellulose-degrading bacteria from biogas slurry and their RAPD profiling. Curr Res Microbiol Biotechnol. 2014;2(4):416-21.
-
Mohammadipour Z, Enayatizamir N, Ghezelbash G, Moezzi A. Bacterial diversity and chemical properties of wheat straw-based compost leachate and screening of cellulase producing bacteria. Waste Biomass Valor. 2021;12(3):1293-302. doi: 10.1007/s12649-020-01119-w.
-
Dwarakanath PR, Rajakumari K, Thiruchelvi R. Isolation and characterization of glucanase producing bacteria from forest tree litter. Res J Pharm Technol. 2021;14(2):916-20. doi: 10.5958/0974-360X.2021.00163.3.
-
Rawway M, Ali SG, Badawy AS. Isolation and identification of cellulose-degrading bacteria from different sources at Assiut Governorate (Upper Egypt). J Eco Heal Env. 2018;6(1):15-24. doi: 10.18576/jehe/060103.
-
Xue C, Zhang Q, Owens G, Chen Z. A cellulose-degrading bacterial strain used to modify rice straw can enhance Cu(II) removal from aqueous solution. Chemosphere. 2020;256:127142. doi: 10.1016/j.chemosphere.2020.127142, PMID 32464362.
-
Liang YL, Zhang Z, Wu M, Wu Y, Feng JX. Isolation, screening, and identification of cellulolytic bacteria from natural reserves in the subtropical region of China and optimization of cellulase production by paenibacillus terrae ME27-1. BioMed Res Int. 2014;2014:512497. doi: 10.1155/2014/512497, PMID 25050355.
-
Manfredi AP, Perotti NI, Martinez MA. Cellulose-degrading bacteria isolated from industrial samples and the gut of native insects from Northwest of Argentina. J Basic Microbiol. 2015;55(12):1384-93. doi: 10.1002/jobm.201500269, PMID 26370071.
-
Jain D, Ravina AA, Bhojiya AA, Chauhan S, Rajpurohit D, Mohanty SR. Polyphasic characterization of plant growth promoting cellulose-degrading bacteria isolated from organic manures. Curr Microbiol. 2021;78(2):739-48. doi: 10.1007/s00284-020-02342-3, PMID 33416972.
-
Karim A, Nawaz MA, Aman A, Ul Qader SAU. Hyperproduction of cellulose-degrading endo (1,4) β-d-glucanase from Bacillus licheniformis KIBGE-IB2. J Radiat Res Appl Sci. 2015;8(2):160-5. doi: 10.1016/j.jrras.2014.06.004.
-
Sethi S, Datta A, Gupta BL, Gupta S. Optimization of cellulase production from bacteria isolated from soil. ISRN Biotechnol. 2013;2013:985685. doi: 10.5402/2013/985685, PMID 25937986.
-
Fathallh Eida MF, Nagaoka T, Wasaki J, Kouno K. Isolation and characterization of cellulose-decomposing bacteria inhabiting sawdust and coffee residue composts. Microbes Environ. 2012;27(3):226-33. doi: 10.1264/jsme2.me11299, PMID 22353767.
-
Kim YK, Lee SC, Cho YY, Oh HJ, Ko YH. Isolation of cellulolytic Bacillus subtilis strains from agricultural environments. ISRN Microbiol. 2012;2012:650563. doi: 10.5402/2012/650563, PMID 23724328.
-
Chien P, Yoo HS, Dykes G, Lee S. Isolation and characterization of cellulose-degrading ability in Paenibacillus isolates from landfill leachate. Malays J Microbiol. 2015;11(2):185-94.
-
Siu Rodas Y, Calixto Romo MLA, Guillen Navarro K, Sanchez JE, Zamora Briseno JA, Amaya Delgado L. Bacillus subtilis with endo cellulase and exocellulase activities isolated in the thermophilic phase from composting with coffee residues. Rev Argent Microbiol. 2018;50(3):234-43. doi: 10.1016/j.ram.2017.08.005, PMID 29289440.